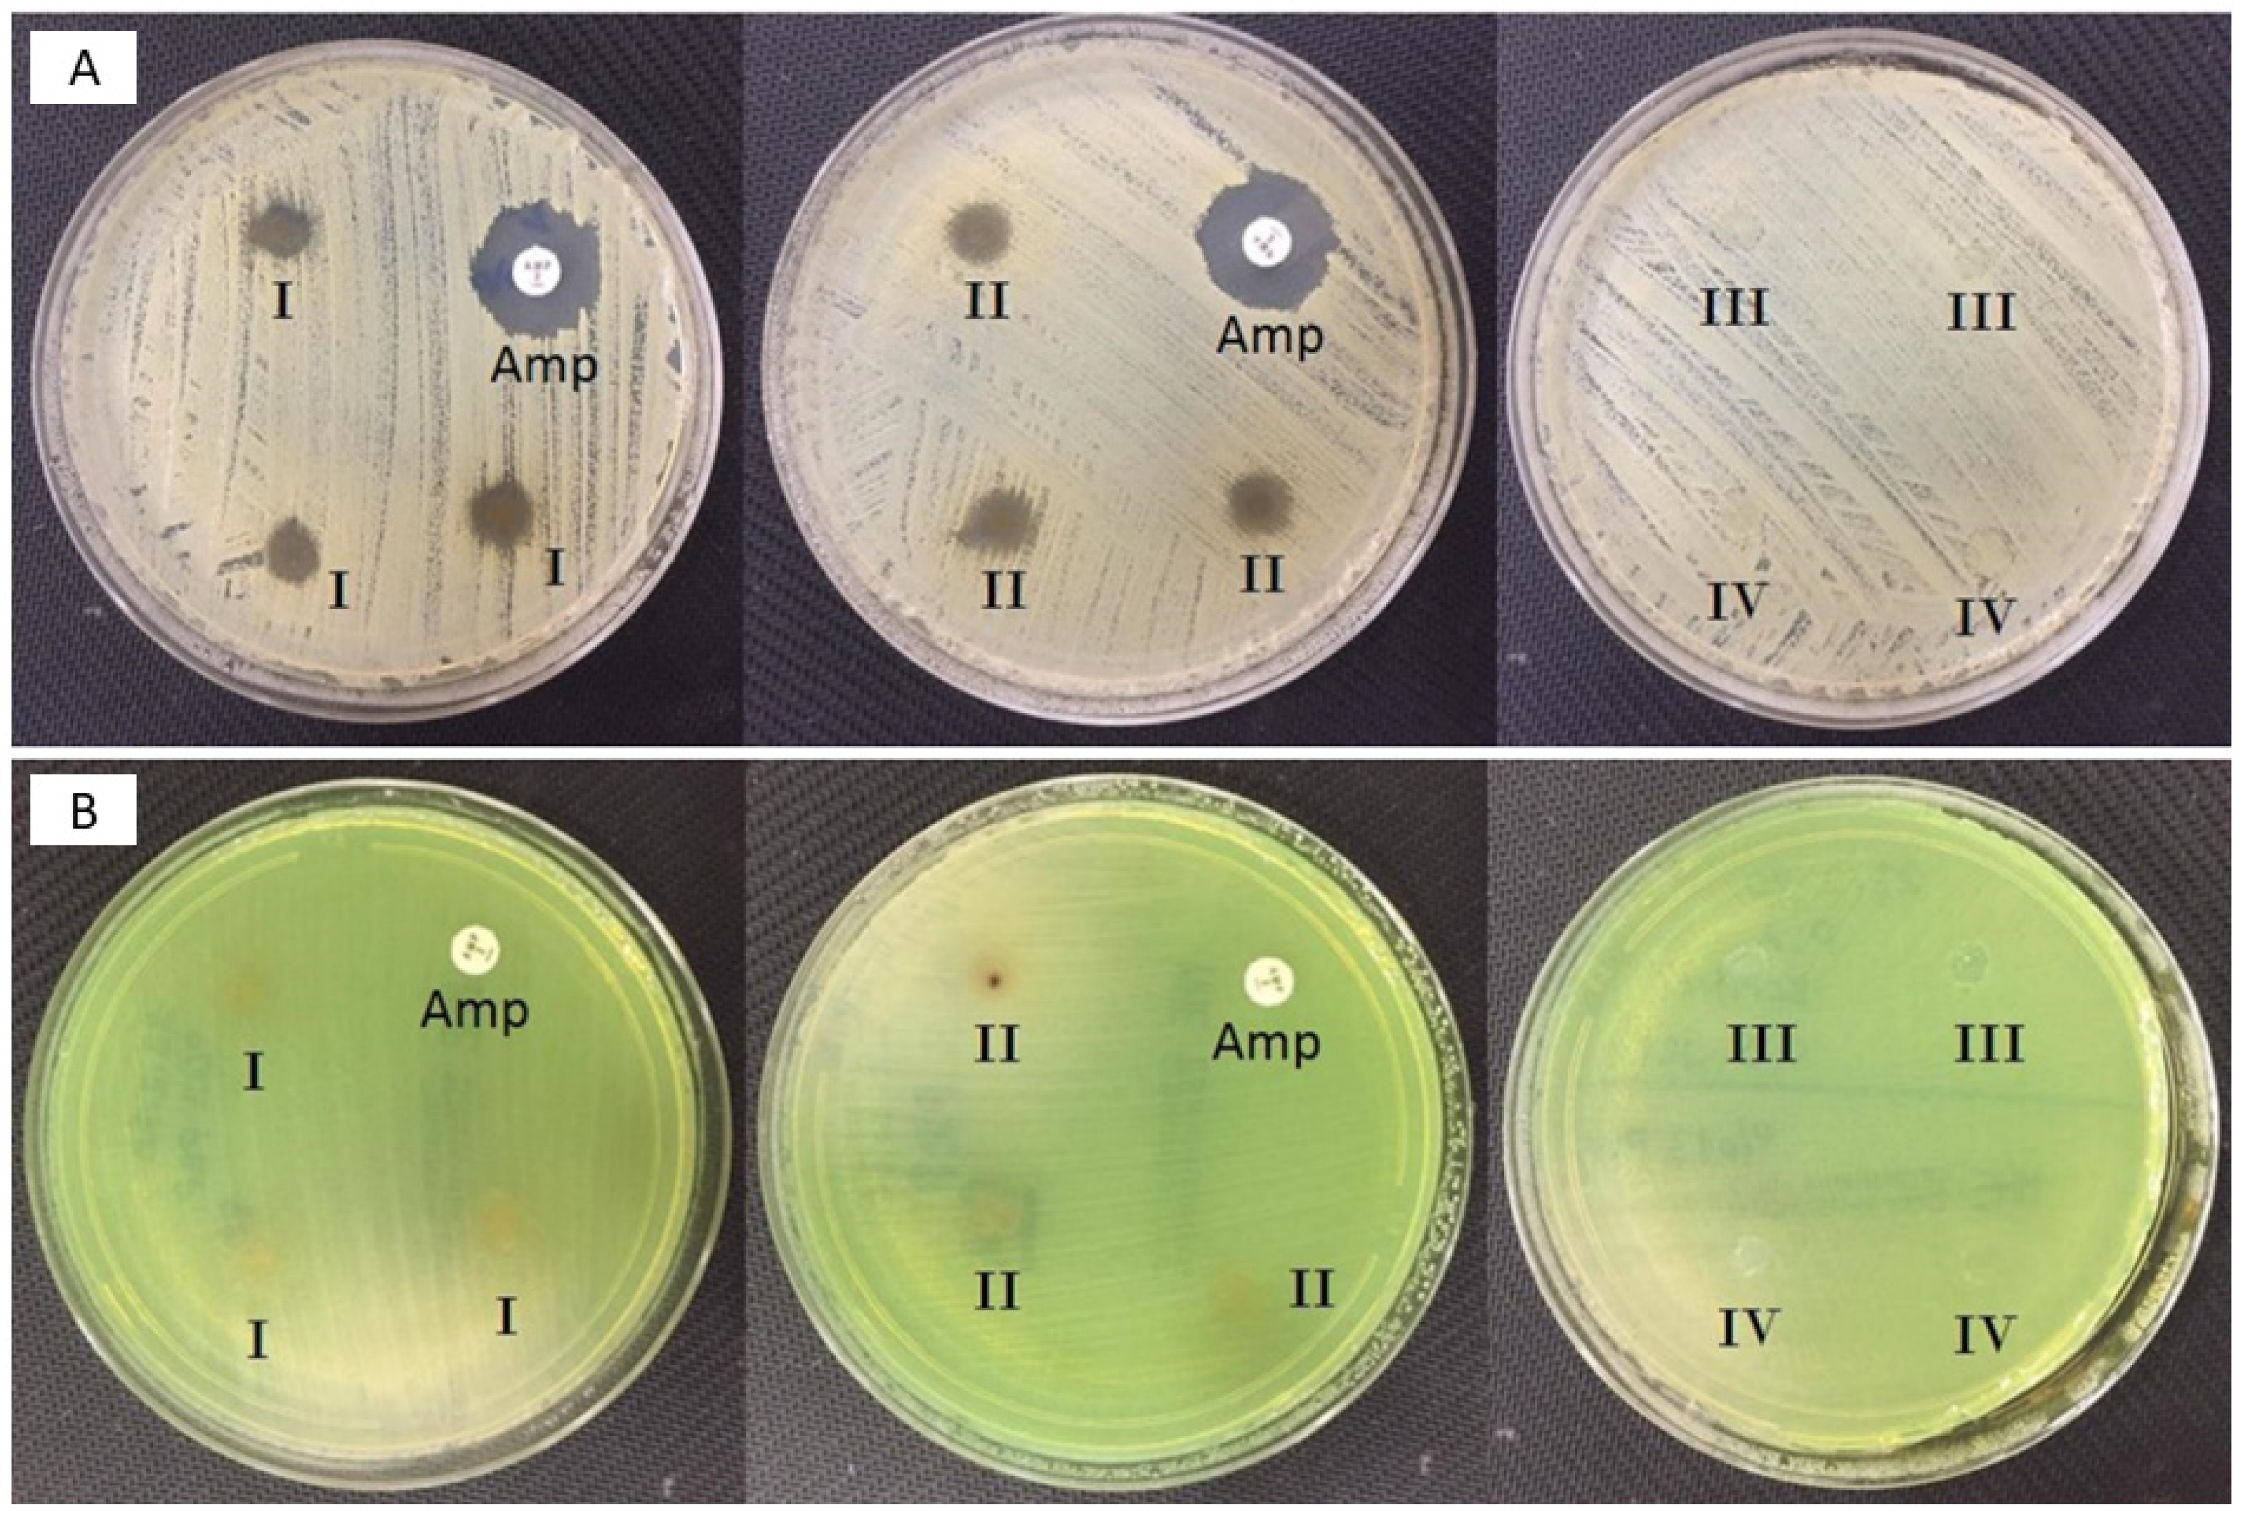
Molecules 26 02577 g004 Molecules 26 02577 g004

Propolis-Based Nanofiber Patches to Repair Corneal Microbial Keratitis
Abstract
1. Introduction
2. Materials and Method
2.1. Materials
2.2. Fabrication and Characterization of the Electrospinning Solutions
2.3. Characterization of the Fabricated Corneal Patches
3. Results and Discussions
3.1. Morphological Properties of the Corneal Patches
3.2. FTIR Analysis
3.3. Thermal Properties of the Corneal Patches
3.4. Antimicrobial Activity of the Fabricated Corneal Patches Against the S. aureus and P. aeruginosa
3.5. Mechanical Properties of the Corneal Patches
3.6. Drug Release Profiles of Propolis
3.7. Biocompatibility Properties of the Corneal Nanofiber Patches
3.8. Surface Wettability Properties of the Corneal Nanofiber Patches
4. Conclusions
Supplementary Materials
Author Contributions
Funding
Acknowledgments
Conflicts of Interest
Sample Availability
References
- Fuest, M.; Yam, G.H.F.; Peh, G.S.L.; Mehta, J.S. Advances in corneal cell therapy. Regen. Med. 2016, 11, 601–615. [Google Scholar] [CrossRef]
- DelMonte, D.W.; Kim, T. Anatomy and physiology of the cornea. J. Cataract Refract. Surg. 2011, 37, 588–598. [Google Scholar] [CrossRef]
- Robaei, D.; Watson, S. Corneal blindness: A global problem. Clin. Exp. Ophthalmol. 2014, 42, 213–214. [Google Scholar] [CrossRef]
- Garg, P.; Krishna, P.V.; Stratis, A.K.; Gopinathan, U. The value of corneal transplantation in reducing blindness. Eye 2005, 19, 1106–1114. [Google Scholar] [CrossRef]
- Whitcher, J.P.; Sirinivasan, M.; Upadhyay, M.P. Corneal blindness: A global perspective. Bull. World Health Organ. 2001, 79, 214–221. [Google Scholar]
- Upadhyay, M.P.; Srinivasan, M.; Whitcher, J.P. Diagnosing and managing microbial keratitis. Community Eye Health J. 2015, 28, 3–6. [Google Scholar]
- Stapleton, F.; Carnt, N. Contact lens-related microbial keratitis: How have epidemiology and genetics helped us with pathogenesis and prophylaxis. Eye 2011, 26, 185–193. [Google Scholar] [CrossRef]
- Robertson, D.M.; Petroll, W.M.; Jester, J.V.; Cavanagh, H.D. The role of contact lens type, oxygen transmission, and care-related solutions in mediating epithelial homeostasis and Pseudomonas binding to corneal cells: An overview. Eye Contact Lens Sci. Clin. Pr. 2007, 33, 394–398. [Google Scholar] [CrossRef]
- Zimmerman, A.B.; Nixon, A.D.; Rueff, E.M. Contact lens associated microbial keratitis: Practical considerations for the optometrist. Clin. Optom. 2016, 8, 1–12. [Google Scholar] [CrossRef]
- Astley, R.; Miller, F.C.; Mursalin, M.H.; Coburn, P.S.; Callegan, M.C. An eye on staphylococcus aureus toxins: Roles in ocular damage and inflammation. Toxins 2019, 11, 356. [Google Scholar] [CrossRef]
- O’Brien, T.P. Management of bacterial keratitis: Beyond exorcism towards consideration of organism and host factors. Eye 2003, 17, 957–974. [Google Scholar] [CrossRef]
- Cesur, S.; Oktar, F.N.; Ekren, N.; Kilic, O.; Alkaya, D.B.; Seyhan, S.A.; Ege, Z.R.; Lin, C.-C.; Kuruca, S.E.; Erdemir, G.; et al. Preparation and characterization of electrospun polylactic acid/sodium alginate/orange oyster shell composite nanofiber for biomedical application. J. Aust. Ceram. Soc. 2019, 56, 533–543. [Google Scholar] [CrossRef]
- Li, W.-J.; Laurencin, C.T.; Caterson, E.J.; Tuan, R.S.; Ko, F.K. Electrospun nanofibrous structure: A novel scaffold for tissue engineering. J. Biomed. Mater. Res. 2002, 60, 613–621. [Google Scholar] [CrossRef] [PubMed]
- Bhattarai, S.R.; Bhattarai, N.; Yi, H.K.; Hwang, P.H.; Cha, D.I.; Kim, H.Y. Novel biodegradable electrospun membrane: Scaffold for tissue engineering. Biomaterials 2004, 25, 2595–2602. [Google Scholar] [CrossRef]
- Heydarkhan-Hagvall, S.; Schenke-Layland, K.; Dhanasopon, A.P.; Rofail, F.; Smith, H.; Wu, B.M.; Shemin, R.; Beygui, R.E.; MacLellan, W.R. Three-dimensional electrospun ECM-based hybrid scaffolds for cardiovascular tissue engineering. Biomaterials 2008, 29, 2907–2914. [Google Scholar] [CrossRef] [PubMed]
- Cesur, S.; Ulag, S.; Ozak, L.; Gumussoy, A.; Arslan, S.; Yilmaz, B.K.; Ekren, N.; Agirbasli, M.; Kalaskar, D.M.; Gunduz, O. Production and characterization of elastomeric cardiac tissue-like patches for Myocardial Tissue Engineering. Polym. Test. 2020, 90, 106613. [Google Scholar] [CrossRef]
- Ilhan, E.; Cesur, S.; Guler, E.; Topal, F.; Albayrak, D.; Guncu, M.M.; Cam, M.E.; Taskin, T.; Sasmazel, H.T.; Aksu, B.; et al. Development of Satureja cuneifolia-loaded sodium alginate/polyethylene glycol scaffolds produced by 3D-printing technology as a diabetic wound dressing material. Int. J. Biol. Macromol. 2020, 161, 1040–1054. [Google Scholar] [CrossRef]
- Yusong, P.; Jie, D.; Yan, C.; Qianqian, S. Study on mechanical and optical properties of poly(vinyl alcohol) hydrogel used as soft contact lens. Mater. Technol. 2016, 31. [Google Scholar] [CrossRef]
- Ulag, S.; Ilhan, E.; Aksu, B.; Sengor, M.; Ekren, N.; Kilic, O.; Gunduz, O. Patch-Based Technology for Corneal Microbial Keratitis. In Proceedings of the Lecture Notes in Computer Science (Including Subseries Lecture Notes in Artificial Intelligence and Lecture Notes in Bioinformatics); Springer: Cham, Switzerland, 2020; Volume 12108, pp. 194–200. [Google Scholar]
- Cesur, S.; Cam, M.E.; Sayın, F.S.; Su, S.; Gunduz, O. Controlled Release of Metformin Loaded Polyvinyl Alcohol (PVA) Microbubble/Nanoparticles Using Microfluidic Device for the Treatment of Type 2 Diabetes Mellitus. In Proceedings of the Lecture Notes in Computer Science (Including Subseries Lecture Notes in Artificial Intelligence and Lecture Notes in Bioinformatics); Springer: Cham, Switzerland, 2020; Volume 12108, pp. 185–193. [Google Scholar]
- Mad-Ali, S.; Benjakul, S.; Prodpran, T.; Maqsood, S. Characteristics and gelling properties of gelatin from goat skin as affected by drying methods. J. Food Sci. Technol. 2017, 54, 1646–1654. [Google Scholar] [CrossRef]
- Pal, K.; Banthia, A.K.; Majumdar, D.K. Preparation and characterization of polyvinyl alcohol-gelatin hydrogel membranes for biomedical applications. AAPS PharmSciTech 2007, 8, E142–E146. [Google Scholar] [CrossRef]
- Huang, C.Y.; Hu, K.H.; Wei, Z.H. Comparison of cell behavior on pva/pva-gelatin electrospun nanofibers with random and aligned configuration. Sci. Rep. 2016, 6, 37960. [Google Scholar] [CrossRef]
- Jain, D.; Carvalho, E.; Banthia, A.K.; Banerjee, R. Development of polyvinyl alcohol-gelatin membranes for antibiotic delivery in the eye. Drug Dev. Ind. Pharm. 2011, 37, 167–177. [Google Scholar] [CrossRef]
- Oliveira, R.N.; McGuinness, G.B.; Rouze, R.; Quilty, B.; Cahill, P.; Soares, G.D.A.; Thiré, R.M.S.M. PVA hydrogels loaded with a Brazilian propolis for burn wound healing applications. J. Appl. Polym. Sci. 2015, 132, 132. [Google Scholar] [CrossRef]
- Albayrak, S.; Albayrak, S. Propolis: Natural antimicrobial matter. Ankara Univ. Eczac. Fak. Derg. 2008, 37, 201–215. [Google Scholar] [CrossRef]
- Fernández, M.C.; Cuesta-Rubio, O.; Perez, A.R.; De Oca Porto, R.M.; Hernández, I.M.; Piccinelli, A.L.; Rastrelli, L. GC-MS determination of isoflavonoids in seven red cuban propolis samples. J. Agric. Food Chem. 2008, 56, 9927–9932. [Google Scholar] [CrossRef]
- Cui-ping, Z.; Shuai, H.; Wen-ting, W.; Shun, P.; Xiao-ge, S.; Ya-jing, L.; Fu-liang, H. Development of High-Performance Liquid Chromatographic for Quality and Authenticity Control of Chinese Propolis. J. Food Sci. 2014, 79, C1315–C1322. [Google Scholar] [CrossRef] [PubMed]
- Huang, S.; Zhang, C.P.; Wang, K.; Li, G.Q.; Hu, F.L. Recent advances in the chemical composition of propolis. Molecules 2014, 19, 19610–19632. [Google Scholar] [CrossRef] [PubMed]
- Marcucci, M.C. Propolis: Chemical composition, biological properties and therapeutic activity. Apidologie 1995, 26, 83–99. [Google Scholar] [CrossRef]
- Cumbao, J.L.T.; Alvarez, P.L.J.; Belina-Aldemita, M.D.; Micor, J.R.L.; Angelia, M.R.N.; Manila-Fajardo, A.C.; Cervancia, C.R. Total phenolics, total flavonoids, antioxidant activity and antibacterial property of propolis produced by the stingless bee, Tetragonula biroi (Friese), from Laguna and Quezon, Philippines. Philipp. Entomol. 2016, 30, 63–74. [Google Scholar]
- Meimandi-Parizi, A.; Oryan, A.; Sayahi, E.; Bigham-Sadegh, A. Propolis extract a new reinforcement material in improving bone healing: An in vivo study. Int. J. Surg. 2018, 56, 94–101. [Google Scholar] [CrossRef]
- Ahlawat, J.; Kumar, V.; Gopinath, P. Carica papaya loaded poly (vinyl alcohol)-gelatin nanofibrous scaffold for potential application in wound dressing. Mater. Sci. Eng. C 2019, 103, 109834. [Google Scholar] [CrossRef]
- Sharaf, S.; El-Naggar, M.E. Wound dressing properties of cationized cotton fabric treated with carrageenan/cyclodextrin hydrogel loaded with honey bee propolis extract. Int. J. Biol. Macromol. 2019, 133, 583–591. [Google Scholar] [CrossRef]
- Derkach, S.R.; Voron’ko, N.G.; Sokolan, N.I.; Kolotova, D.S.; Kuchina, Y.A. Interactions between gelatin and sodium alginate: UV and FTIR studies. J. Dispers. Sci. Technol. 2020, 41, 690–698. [Google Scholar] [CrossRef]
- Linh, N.T.B.; Lee, B.T. Electrospinning of polyvinyl alcohol/gelatin nanofiber composites and cross-linking for bone tissue engineering application. J. Biomater. Appl. 2012, 27, 255–266. [Google Scholar] [CrossRef]
- Ang, L.F.; Darwis, Y.; Por, L.Y.; Yam, M.F. Microencapsulation curcuminoids for effective delivery in pharmaceutical application. Pharmaceutics 2019, 11, 451. [Google Scholar] [CrossRef]
- Bonilla, J.; Bittante, A.M.Q.B.; Sobral, P.J.A. Thermal analysis of gelatin–chitosan edible film mixed with plant ethanolic extracts. J. Therm. Anal. Calorim. 2017, 130, 1221–1227. [Google Scholar] [CrossRef]
- Do Nascimento, T.G.; da Silva, P.F.; Azevedo, L.F.; da Rocha, L.G.; de Moraes Porto, I.C.C.; Lima e Moura, T.F.A.; Basílio-Júnior, I.D.; Grillo, L.A.M.; Dornelas, C.B.; da Fonseca, S.E.J.; et al. Polymeric Nanoparticles of Brazilian Red Propolis Extract: Preparation, Characterization, Antioxidant and Leishmanicidal Activity. Nanoscale Res. Lett. 2016, 11, 1–16. [Google Scholar] [CrossRef] [PubMed]
- Gupta, S.; Pramanik, A.K.; Kailath, A.; Mishra, T.; Guha, A.; Nayar, S.; Sinha, A. Composition dependent structural modulations in transparent poly(vinyl alcohol) hydrogels. Colloids Surfaces B Biointerfaces 2009, 74, 186–190. [Google Scholar] [CrossRef] [PubMed]
- Archondouli, P.S.; Kallitsis, J.K.; Kalfoglou, N.K. Compatibilization and property characterization of polycarbonate/polyurethane polymeric alloys. J. Appl. Polym. Sci. 2003, 89, 287. [Google Scholar] [CrossRef]
- Sadeghi, A.; Pezeshki-Modaress, M.; Zandi, M. Electrospun polyvinyl alcohol/gelatin/chondroitin sulfate nanofibrous scaffold: Fabrication and in vitro evaluation. Int. J. Biol. Macromol. 2018, 114, 1248–1256. [Google Scholar] [CrossRef]
- Arıkan, H.K.; Solak, H.H. Propolis Extract-PVA Nanocomposites of Textile Design: Antimicrobial Effect on Gram Positive and Negative Bacterias. Int. J. Second. Metab. 2017, 4, 218–224. [Google Scholar] [CrossRef]
- Silici, S.; Kutluca, S. Chemical composition and antibacterial activity of propolis collected by three different races of honeybees in the same region. J. Ethnopharmacol. 2005, 99, 69–73. [Google Scholar] [CrossRef]
- Aranci, K.; Uzun, M.; Su, S.; Cesur, S.; Ulag, S.; Amin, A.; Guncu, M.M.; Aksu, B.; Kolayli, S.; Ustundag, C.B.; et al. 3D Propolis-Sodium Alginate Scaffolds: Influence on Structural Parameters, Release Mechanisms, Cell Cytotoxicity and Antibacterial Activity. Molecules 2020, 25, 5082. [Google Scholar] [CrossRef] [PubMed]
- Kim, J.I.; Pant, H.R.; Sim, H.J.; Lee, K.M.; Kim, C.S. Electrospun propolis/polyurethane composite nanofibers for biomedical applications. Mater. Sci. Eng. C 2014, 44, 52–57. [Google Scholar] [CrossRef]
- Ulag, S.; Ilhan, E.; Sahin, A.; Karademir Yilmaz, B.; Kalaskar, D.M.; Ekren, N.; Kilic, O.; Nuzhet Oktar, F.; Gunduz, O. 3D printed artificial cornea for corneal stromal transplantation. Eur. Polym. J. 2020, 133, 109744. [Google Scholar] [CrossRef]
- Ilhan, E.; Ulag, S.; Sahin, A.; Yilmaz, B.K.; Ekren, N.; Kilic, O.; Sengor, M.; Kalaskar, D.M.; Oktar, F.N.; Gunduz, O. Fabrication of tissue-engineered tympanic membrane patches using 3D-Printing technology. J. Mech. Behav. Biomed. Mater. 2021, 114, 104219. [Google Scholar] [CrossRef] [PubMed]
- Mishima, S.; Narita, Y.; Chikamatsu, S.; Inoh, Y.; Ohta, S.; Yoshida, C.; Araki, Y.; Akao, Y.; Suzuki, K.M.; Nozawa, Y. Effects of propolis on cell growth and gene expression in HL-60 cells. J. Ethnopharmacol. 2005, 99, 5–11. [Google Scholar] [CrossRef]
- Unal, S.; Arslan, S.; Karademir Yilmaz, B.; Kazan, D.; Oktar, F.N.; Gunduz, O. Glioblastoma cell adhesion properties through bacterial cellulose nanocrystals in polycaprolactone/gelatin electrospun nanofibers. Carbohydr. Polym. 2020, 233, 115820. [Google Scholar] [CrossRef] [PubMed]
- Wu, G.; Yang, Y.; Lei, Y.; Fu, D.; Li, Y.; Zhan, Y.; Zhen, J.; Teng, M. Hydrophilic nano-SiO2/PVA-based coating with durable antifogging properties. J. Coat. Technol. Res. 2020, 17, 1145–1155. [Google Scholar] [CrossRef]
- Ino, J.M.; Sju, E.; Ollivier, V.; Yim, E.K.F.; Letourneur, D.; Le Visage, C. Evaluation of hemocompatibility and endothelialization of hybrid poly(vinyl alcohol) (PVA)/gelatin polymer films. J. Biomed. Mater. Res. Part B Appl. Biomater. 2013, 101, 1549–1559. [Google Scholar] [CrossRef]
- Jiang, H.; Zuo, Y.; Zhang, L.; Li, J.; Zhang, A.; Li, Y.; Yang, X. Property-based design: Optimization and characterization of polyvinyl alcohol (PVA) hydrogel and PVA-matrix composite for artificial cornea. J. Mater. Sci. Mater. Med. 2014, 25, 941–952. [Google Scholar] [CrossRef] [PubMed]
- Kim, J.; Shin, D.H.; Lee, W.J. Suicidal ideation and occupational pesticide exposure among male farmers. Environ. Res. 2014, 128, 52–56. [Google Scholar] [CrossRef] [PubMed]
- Bilginer, R.; Arslan Yildiz, A. A facile method to fabricate propolis enriched biomimetic PVA architectures by co-electrospinning. Mater. Lett. 2020, 276, 128191. [Google Scholar] [CrossRef]

Publisher’s Note: MDPI stays neutral with regard to jurisdictional claims in published maps and institutional affiliations. |
© 2021 by the authors. Licensee MDPI, Basel, Switzerland. This article is an open access article distributed under the terms and conditions of the Creative Commons Attribution (CC BY) license (https://creativecommons.org/licenses/by/4.0/).
Share and Cite
Ulag, S.; Ilhan, E.; Demirhan, R.; Sahin, A.; Yilmaz, B.K.; Aksu, B.; Sengor, M.; Ficai, D.; Titu, A.M.; Ficai, A.; et al. Propolis-Based Nanofiber Patches to Repair Corneal Microbial Keratitis. Molecules 2021, 26, 2577. https://doi.org/10.3390/molecules26092577
Ulag S, Ilhan E, Demirhan R, Sahin A, Yilmaz BK, Aksu B, Sengor M, Ficai D, Titu AM, Ficai A, et al. Propolis-Based Nanofiber Patches to Repair Corneal Microbial Keratitis. Molecules. 2021; 26(9):2577. https://doi.org/10.3390/molecules26092577
Chicago/Turabian StyleUlag, Songul, Elif Ilhan, Ramazan Demirhan, Ali Sahin, Betul Karademir Yilmaz, Burak Aksu, Mustafa Sengor, Denisa Ficai, Aurel Mihail Titu, Anton Ficai, and et al. 2021. "Propolis-Based Nanofiber Patches to Repair Corneal Microbial Keratitis" Molecules 26, no. 9: 2577. https://doi.org/10.3390/molecules26092577
APA StyleUlag, S., Ilhan, E., Demirhan, R., Sahin, A., Yilmaz, B. K., Aksu, B., Sengor, M., Ficai, D., Titu, A. M., Ficai, A., & Gunduz, O. (2021). Propolis-Based Nanofiber Patches to Repair Corneal Microbial Keratitis. Molecules, 26(9), 2577. https://doi.org/10.3390/molecules26092577

